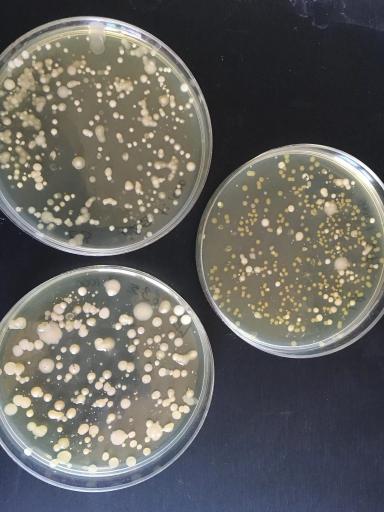

Исследование ризобиома диких пшениц в Краснодарском крае
В ходе недавней совместной экспедиции на Таманский полуостров, учёные КубГАУ, КубГУ и научно-производственной фирмы ООО «ДНК Экспертиза» обнаружили места произрастания редких видов семейства Злаковых: беотийской пшеницы (или таудара) (Triticum boeoticum) и пшеницы однозернянки (Triticum monococcum). Оба эти родственные вида являются древнейшими возделываемыми злаковыми культурами, давшими начало всему современному разнообразию сортов одомашненной пшеницы. Обнаруженные локальные популяции являются следами древних земледельческих культур, занимавшихся выращиванием таудара и однозернянки на Юге России тысячи лет назад. Последний раз находки беотийской пшеницы на территории края были сделаны более тридцати лет назад и с тех пор этот вид считался исчезнувшим на Кубани. Таудар занесён в Красные книги Краснодарского края, Республики Крым, Севастополя и, ранее, в Красную книгу СССР. Поэтому вновь найденные локальные популяции на побережье Таманского полуострова от косы Тузла до мыса Панагия представляют большой интерес,как возможный источник новых генетических ресурсов для селекционеров.
Собранный материал пополнит гербарный фонд двух ведущих ВУЗов Краснодарского края. Одновременно со сбором растений, были собраны образцы почв, на которых произрастают найденные виды. Эти образцы позволят ученным КубГАУ в новой лаборатории молекулярно-генетических исследований в АПК изучить, с применением метагеномных подходов, видовой состав бактериальных сообществ ризосферы и ризопланы предков современной пшеницы. Цель этой части работ — найти и исследовать бактерии, обладающие совокупностью полезных для растений свойств, так называемые PGPR (Plant growth promoting rhizobacteria – ризобактерии способствующие росту растений). Интерес к этим микроорганизмам увеличивается год от года и мировые лидеры наукоёмких технологий в сельском хозяйстве, в частности, концерн Байер АГ (Германия) ускоренными темпами разрабатывают препараты на основе живых PGPR, в том числе и для культивирования озимых пшениц. Выделенные учёными КубГАУ бактериальные штаммы в будущем могут стать основой отечественных инновационных препаратов для семеноводства. Важно, что изначально при разработке этих препаратов во внимание принимаются климатические и почвенные уcловия Краснодарского края. Сотрудники Университета планируют так же осуществить в положенные сроки сбор образцов зерна и интродуцировать данные виды на участках Опытного поля КубГАУ для проведения дальнейших исследований.

Нет комментариев